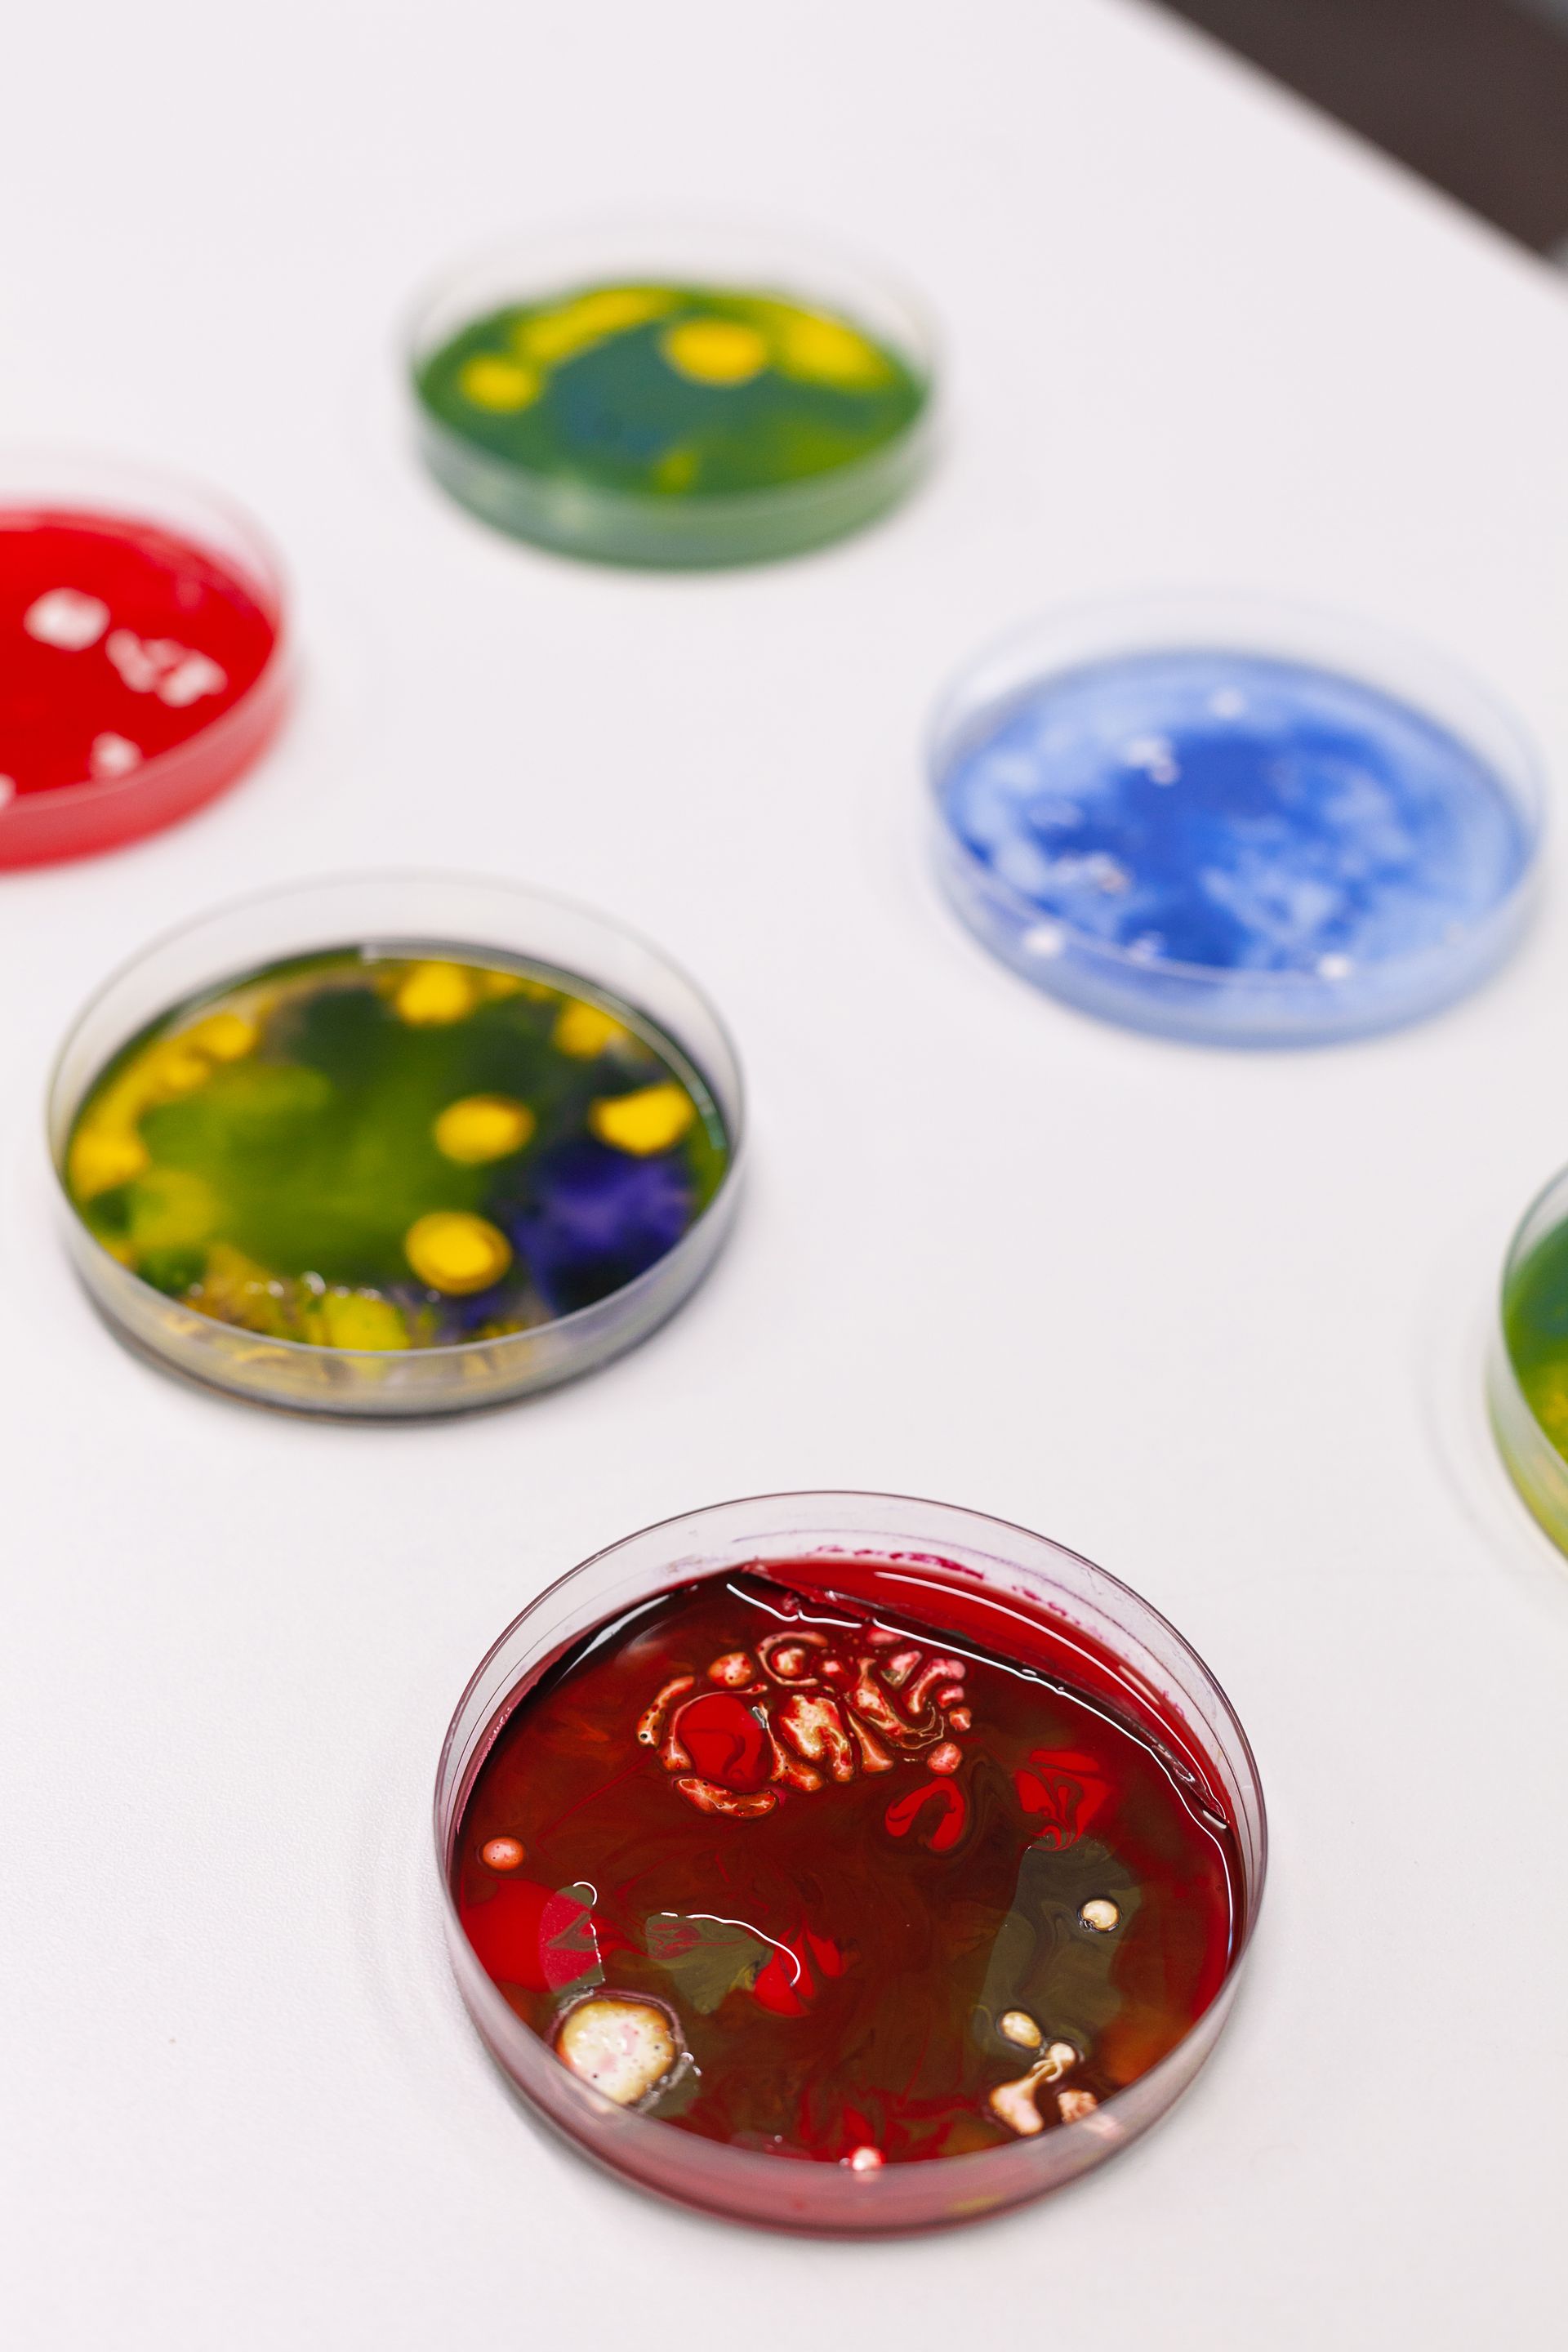
Une rangée de boîtes de Pétri remplies de liquides de différentes couleurs

Café des Sciences - ZOONOSES
Date de l'événement : 28 août
Horaires : 18h
Lieu : Café de la Gare
Organisateur : La Canopée des Sciences
Intervenant : Edouarda PIERRE-ALEXANDRE
Et si votre santé était liée à celles des animaux ?

Une catégorie de pathogènes se transmettent entre animaux et humains et vice-versa. Les différents microorganismes et animaux impliqués ainsi que les différents modes de transmissions seront évoqués de manière très large. Ces concepts seront illustrés par des cas liés au bassin amazonien. Aussi, certains enjeux liés à la détection de ces pathogènes sera développé. Enfin, quelques exemples d’actions de prévention clôtureront cette intervention.
Une présentation par Edouarda PIERRE-ALEXANDRE
Doctorante à l'université de Guyane dans l'équipe de recherche TBIP (Tropical Biome and Immuno Physiopathology) depuis moins d'un an. L'équipe TBIP est centrée sur le concept de "One Health" qui associe les interactions entre la santé humaine, la santé animale et l'environnement. En plus de cela, TBIP développent des outils de diagnostiques innovant afin de répondre aux spécificités du territoire guyanais.